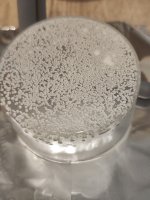
90dc670d-fecd-4885-aef2-28dd3c4a9f82.jpg 90dc670d-fecd-4885-aef2-28dd3c4a9f82.jpg

psilocybin
Rising Star
Any questions or problems you may run into during an extraction can be asked to get other members input in this thread.

I’m new to the group so forgive me if I’m not familiar with the rules or maps in the site! I do want to know where to go or who to ask about brands for naphtha and extraction teksGreetings to all new members and guests,
It's been noticed the influx of new members as well as visiting guests. This post is to invite you all to participate in this community if you feel so inclined. You are welcome here, as long as you abide by the guidelines. Though you may feel there's reason for it, there's really no need to be shy. This is a very open community, with people from all walks of life. Guests, in order to take advantage of all this, you'll need to create an account, so, stop being a creeper! Laughing Twisted Evil
A few notes:
1. Hop in the chat - The chat function is a wonderful way to congregate with members of the community, old and new.The more people in the chat, the better. It's one of those things that needs a little momentum. Sometimes it can be a little slow, but keeping the chat open usually brings little gems of reward. So in your downtime, while your feet are kicked up and you're relaxing, pop the chat open. It can't hurt. The other nice thing about the chat is the ability to open private rooms to be able to discuss things with members you resonate with the most, in real time. Connect, ask questions, be mindful, respectful, and considerate, and have fun. Learn, share, expand Smile The chat button can be found at the uppermost left-hand corner of your the main forum web page.
2. The questionnaire - This is an exercise to 1. help you develop autonomy in your own understanding about many things, though the questionnaire is centered around psychedelics; the skills it encourages can be used in many different ways. And 2. To help you get an understanding for the type of culture that is fostered here. We are very concerned with thoughtful approaches to most things.
3. Your expectations: Naturally, in engaging in a forum, we expect some interaction. Because this is an online forum, and the main form of communication is text based, conversations can be a little slower. So if you post, be patient in waiting for a response, and make sure to limit your expectations; it may take a while for your post to be noticed and for someone to respond, and sometimes no one has anything to say. And that's okay. It's not something to take personally or to become upset about. It's natural to perhaps be a little disappointed, but that shouldn't hinder future interactions. Don't give up simply because your expectations in a very specific instance were not met. Also, while there are some very bright and brilliant minds here, there's no need to be intimidated. This is a place of camaraderie, not competition. We are all valued the same here.
4. Here are some links that can help you along the way at the Nexus: [IMPORTANT] No buying/selling/procuring, why? [IMPORTANT] New chat rules, [REMINDER]: New members/registrants - The DMT-Nexus Ruleset, Posting Etiquette, Post Structure, and Swimmers , The Essential DMT Guide, IMPORTANT: How to ask questions, Welcome new members! , Attitude Page, DMT-Nexus Wiki, Forum Search Function.
So, come join us Love
One love
Otherwise known as "floaters" ... I get them sometimes and have heard they are caused by too fast cooling of the NPS, some recommend going to the fridge first for a couple of hours, to get crystal growth going on the dish rather than suspended. I've also seen wrapping the dish in cloth before putting in the freezer recommended as a way of slowing the cooling down to ensure larger crystals.But somehow all the crystals are swimming around in the middle of the NPS horizontal.
Iirc it's roughly 30mg per ml at room tempHm, I had it in the fridge first for more then 30 minutes then over to freezer....
2nd strange thing is that nothing sits at the Glas or ground....
Could have been that a few drops of water wash h2o made it over.
Ok I found something over here
Having trouble getting my crystals to stick to dish..
This is my latest and probably best yield, haven't weighed it out yet but it appears to be almost double what I have been getting. I've been using heavily reused naphtha I think that's what's causing the off-white color. 50g ACRB using Cyb's tek. But I always seem to have this issue where the...forum.dmt-nexus.me
Besides that, how much mg DMT is hold by naptha ml? in the wiki or a thread with or by brennendeswasser it was said about 2g is this a typo and 2mg are ment for a ml Naptha?
if I recall correctlyWhat does lirc mean?
Probably. The losses will include whatever DMT remains dissolved in your naphtha after freezing.A) The recrystallization was a loss of 10mg while using fresh not before used naptha.
Does that mean that the product was already pretty clean before the recrystall?
DMT salts tend to be highly soluble in water, but the exact figure depends on the acid being used. I suspect many DMT salts will be far more soluble than the figure you give, plus you need to specify a temperature to make the figures properly useful.B) is it ~correct what I found, that 100ml acidic water holds about 1,5g DMT? (15g for a liter)